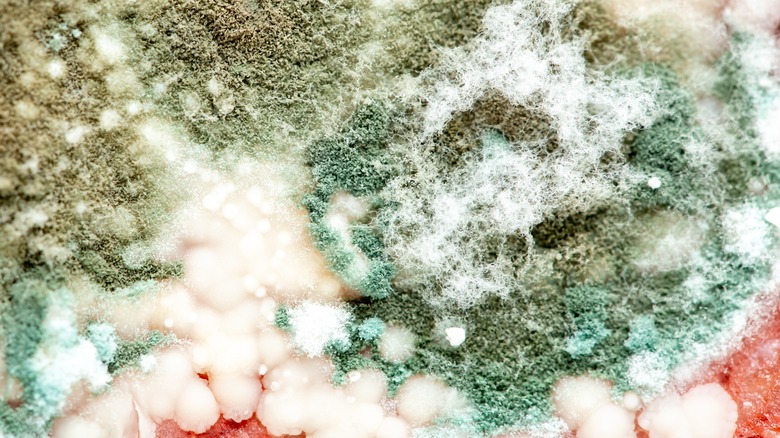

Your Ultimate Guide To The Hot Sauce Fermentation Process
We may receive a commission on purchases made from links.
Fermentation is a beautiful thing. Though it seems to be at the forefront of food trends across many countries, fermentation has been a staple foundation in numerous cuisines long before refrigeration and the artisan sourdoughs of today came into fashion.
When it comes to hot sauce, can there ever really be too much tang? While this lip-smacking, palette-pleasing quality can be achieved through the addition of vinegar, fermentation can take those flavors to the next level. Experts Pao Liu and Helen Graves agree and are known for using fermentation in their work, so I've consulted them for this guide to all things hot sauce fermentation.
Pao Liu is a London-based fermentation specialist and small business owner of Pao Pop' n' Pickles. Liu makes and sells her own ferments and sauces and teaches workshops on the wide-ranging process of fermentation. Helen Graves is a recipe developer for Great British Chefs, founder and editor of Pit Magazine, and author of "Live Fire" and the soon-to-be-released "BBQ Days, BBQ Nights." If you are thinking of making your own fermented hot sauce, read on to learn more about the process. Now might be the perfect time to consider what hot peppers to plant, with the aim of turning their yields into flavorful sauces after harvest.
The difference between fermented hot sauce and just hot sauce
Anyone reading this article probably already agrees that hot sauce is often the secret sauce used to enhance many savory dishes from across a wide range of cuisines. The key difference between fermented hot sauce and vinegar-based hot sauces boils down to the process by which they are made. As fermentation takes time and patience, it goes without saying that hot sauces that avoid this process can be made more quickly and efficiently and will still taste delicious.
However, good things come to those who wait. While more time-consuming, fermented hot sauces tend to have more layers of flavor, including that ubiquitous tanginess that keeps us returning to the bottle for more. These flavors develop over time during the fermentation process. Therefore, it can be worth going the extra step if making your own batches of hot sauce at home. While it is time-consuming, aside from a few lid-opening "burps" to release pent-up gasses, most of the work is hands-off, done by chemistry and time rather than human labor.
How does lacto-fermentation work?
Liu, who studied the art and science of fermentation from Sandor Katz himself, explains, "Lacto-fermentation is when an environment is suitable for lactic acid bacteria to thrive and multiply when it's in an anaerobic environment and starch is present. The process that releases the lactic acid, which breaks down the vegetables." The results of lactic acid, are the sour taste we know and love from foods like pickles, sauerkraut, and kimchi.
Not just for flavor, Liu tells us. There are other benefits of Lacto-fermentation that work to extend the shelf life of whatever has been fermented. She says, "After the process, the PH drops, and that preserves the vegetables and nutrients, which was an important discovery for humankind. Carbon dioxide is also created during the fermentation process."
There are many types of produce eaten around the globe that have benefited from the Lacto-fermentation process. Cucumbers become pickles. Lemons transform into preserved lemons. Cauliflower morphs into giardiniera. Plums evolve into umeboshi. This flavor-enhancing process makes you look at produce differently and wonder what new creations can be achieved through the fermentation process.
What chile peppers you should choose for hot sauce
When it comes to making hot sauce, there are many varieties of chiles, both fresh and dried, that work well. Graves is known for her love of scotch bonnet chilies and her ability to use them for maximum flavor-meets-heat. She says, "What I love about them is their distinctive fruity flavor. Sure, they're hot, but they're also incredibly aromatic. They pair particularly well with tropical fruits, which also have the benefit of adding some sweetness."
Not just for scotch bonnets, Graves says any chile peppers can be used. Hot sauce isn't just about heat, it's about flavor. Graves suggests experimenting with a few kinds of chiles, which can balance out the heat by incorporating some milder chiles, while still harnessing the flavor of bolder kinds like scotch bonnets.
Organic, homegrown, or reputable farmers' market chiles are ideal to avoid unnecessary pesticides, contaminants, or coatings that could also interfere with the fermentation process. If using only dried chiles, you'll want to select a salt brine over the mash method and a few fresh ingredients, even if not using fresh chiles, as this will work to rehydrate the chile and jumpstart all of its microbes in the process. Overall, the thinner the skin of your chile, the smoother the final sauce. You'll also want to consider the pepper's heat, using this as a helpful marker to decide whether or not to include the heat-packed membrane and often bitter-tasting seeds or remove them.
What other ingredients should you consider?
Liu says, "There are really no rules. You can add fruit purée, tomatoes, carrots or even coffee grounds, some leftover vegetables, and any kind of spices you fancy, depending what kind of sauce you are making. Of course garlic always goes well with chilies."
Graves echoes these sentiments, remarking that it all comes down to individual preferences and palates. She says, "While it's nice to make a "pure" chile hot sauce, I also tend to add some ingredients as standard, garlic being one of them. You could also add spices, herbs, and/or other vegetables."
In Grave's first cookbook, "Live Fire," one example that embraces a few key ingredient suggestions is her recipe for fermented hot garlic honey. It calls upon the balance of scotch bonnets, garlic, and honey, all of which are enhanced through the process of fermentation and time. The results are a heat-packed hot honey with sweet notes of garlic that can be added to just about anything. As Liu and Graves suggest, it helps to work backward and consider the flavors you enjoy and how you'd like to use the end product. Letting those ideas guide you in choosing ingredients may lead you to some delicious and unexpected results.
Which hot sauce style works best
Home fermenters are spoiled for choice when choosing which hot sauce style to inspire them. Depending on which part of the world you focus on, there are as many hot sauce styles as there are foods to cover in the tongue-tingling sauce, most of which can be fermented for extra flavor. It all depends on what flavors you're looking to create or enhance.
Shatta, made from chiles and salt, is from Syrian, Palestinian, Lebanese, and Jordanian regions. The mixture is fermented via time spent in the sun or at room temperature before olive oil, fresh herbs, and acids like vinegar or lemon juice. Other hot sauce styles that can inspire a fermented alternative include herbaceous schug from Yemen, which uses fresh green chiles, and a generous amount of herbs, garlic, and lemon to create a bright and bold sauce. Earthy, heavily spiced harissa from North Africa could also be achieved by fermenting red chiles and garlic and then adding spices like cumin, coriander, and cilantro the the final results. Equally, there's sriracha, which benefits from the power of fermented red chiles, blended with garlic, vinegar, and sugar.
Scotch bonnet-based hot sauces from the Caribbean are known for their fruity flavor and punch of heat and benefit from the additional acidity that fermentation provides. This style has undoubtedly influenced hot sauce styles like buttery and tangy Buffalo and Louisiana-style hot sauce varieties and the base style of the ubiquitous acidity-packed Tabasco hot sauce.
What equipment do you need to ferment hot sauce?
You'll need just a few essential items to safely and successfully ferment at home. Liu breaks it down to two essential items, "a glass jar [and] blender." Depending on how you plan to ferment, a kitchen scale is handy for weighing your ingredients and measuring what percentage of salt should be added. Kitchen gloves are helpful, too, depending on your choice of chiles.
While you don't need specialist fermentation jars to make your own sauces at home, you will want to ensure you have cleaned and sterilized glass jars, free from rust or damage, with seal-tight lids. These jars should also be slightly bigger than the final volume of your ingredients to allow for the gas buildup that comes with the fermentation process. Remember, you will need to open the jars every few days to "burp" your concoction, allowing the gas buildup to release. For your fermented hot sauces' final form, you may want to consider bottles with a built-in stopper, known as "woozy" bottles, or hold onto your old hot sauce containers for future use.
You'll also need a blender, a fine sieve or cheesecloth, and, ideally, some sort of funnel to help get your liquid from the blender into your bottles with as little mess as possible. PH strips are helpful for those who would like to double-check that the pH levels are under 4.0. You can also tell by taste, looking for that hit of acidity.
How to process your chiles
Rinse your peppers to remove any possible chemicals or coating on the skin, then pat dry and remove any stems. When blending, you may also want to de-seed the peppers to reduce the risk of bitterness or a fibrous or pithy texture in the final sauce.
If you'd like to add a layer of sweet smokiness to your hot sauce, charring or roasting your peppers on the grill, in the oven, or by carefully using the open flame on a gas stove, add dimension and depth of flavor. You'll want to combine these charred peppers with a few uncharred ones or other fresh ingredients like tomatoes, garlic, or fruits to boost the sauce's ferment-loving microbes. If you add a char, all ingredients must be cooled to room temperature before continuing. At this stage, you'll also want to decide whether you are keeping your ingredients whole and using a salt brine process or if you need to chop or blend them into a mash or paste if using the mash or dry brine method.
What is a salt brine for hot sauce fermentation?
Using a salt brine is an easy dump-and-go method. Add all ingredients (chiles, garlic, tomatoes, fruits) selected for the initial fermentation process, left whole or in large chunks, to a glass jar. Then, fully submerge them in a concoction of salt and water. Glass fermentation weights might be helpful here.
Salt brines are generally used for longer ferments or with more robust flavored ingredients that can have the potential for slight dampening of flavor. Like Graves details in her recipe for Lacto-fermented chili sauce, whole chile peppers can first be fermented through a salt brine, taking good care to release any pent-up gas by "burping" the jars every few days by opening up the lid. After around 10 days, the fermented whole chiles can be split into two sauces. The first is chopped into a rough paste to create a spicy, tangy paste. The remaining half can be fully blended until smooth alongside some fermenting liquid. If using a salt brine, the ingredients must remain fully submerged to eliminate the risk of contamination and mold and ensure the fermentation process occurs throughout the entire jar.
What is a mash for hot sauce fermentation?
When it comes to fermentation, there's more than just one way to go about the process. You can also employ a dry salt brine or mash instead of a wet brine. This process often involves using 2% to 10% of the total weight of peppers and whatever other ingredients you intend to ferment to enhance the sauce's flavor. Generally speaking, higher ratios of salt are more prevalent in hotter climates and longer fermentations, where they might be needed to help control mood or yeast. If applying this method, creating a mash, paste, or a more finely chopped mixture of ingredients will ensure the fermentation process is executed consistently, effectively, and as swiftly as possible.
This "mash" method is often applied to hot sauces as it can create a more robust and flavorful result. Neither method is wrong; there are just varied applications and reasons for choosing one or the other. The correct hot sauce fermentation method is in the eye of the jar holder.
How long the fermentation process takes
There is no one-size-fits-all answer when it comes to the fermentation process. But the long and short of it is you can't rush science. When it comes to fermentation, there are a few factors to consider, including the thickness of your chile skins, the temperature of the room your jars are sitting in, the percentage of salt you're using, and, ultimately, the flavor profile you hope to develop. These factors will impact how long you leave your hot sauce ingredients to ferment.
Liu says, "It can take from two weeks to a few months. The longer it goes, the rounder flavor goes, and the more acidic it gets. I generally do six weeks at room temperature for Pao Pop N Pickles Sriracha sauce." Graves's recipe for fermented hot garlic honey, from her cookbook "Live Fire," suggests fermenting for 10 days. For those looking for more subtle heat, you can also make a fermented salsa, a slightly quicker process that relies more on the flavor of tomatoes, with chiles working to create a milder background heat. Fermented salsas can be ready in as little as two days.
What steps should you take after the fermentation is complete?
Once the chiles and other ingredients have completed the fermentation process, achieving the desired tangy flavor, you have a few options to consider. First, make sure to taste your final product and adjust the seasonings. Generally speaking, it won't need any extra salt, but it's still helpful to taste it first. This is also the time to use other seasons or sauces like fish sauce or miso. Some add sugar to their hot sauces, but be aware that this can encourage further fermentation if not accounted for through storage options like refrigeration.
Many fermented hot sauces are then preserved by adding vinegar, which can also enhance flavor, depending on taste preferences. Liu says, "Vinegar would generally do the job to keep the shelf life last longer." Graves adds, "There's no need to use additives due to the high salt content of the sauce, but do keep it in the fridge — both to keep it fresh and stop fermentation."
Depending on what is added to the fermented hot sauce, you can store it at room temperature, but note this may continue the fermentation process, changing the overall taste and color of the final product, especially if temperatures vary. Refrigeration tends to be the safest and most reliable option. It also extends the shelf life of your hot sauce for up to three months (if it lasts that long).
What safety precautions to consider when fermenting hot sauce
There are two stages of safety precautions to address. The first is during the initial process, which can have adverse effects if mishandled. Liu, whose business makes a popular fermented sriracha sauce, suggests using gloves when working with chiles. This will protect delicate areas like under your nails and avoid mishaps like accidentally spreading the stinging power of raw chiles to your face or eyes.
The second stage is during the fermenting process itself. Graves notes that before starting the process, it's crucial to sterilize the jars to prevent the sauce from spoiling. Thankfully there are some superheroes working from the inside out to keep the contents safe. Graves says, "The salt content of a fermented sauce is necessary to stop the 'bad' guys from proliferating in your sauce." However, in order for the salt to do its job, Graves reminds us it's crucial that all ingredients remain under the brine. Air exposure equals a risk of mold with fermenting with salt brine.
Metal can also tamper with the fermenting process, so it may be worth investing in fermenting weights, purposefully made from glass, to help keep ingredients submerged and avoid contamination. As Graves noted, this is also not a time to scrimp on the amount of salt used, as doing so can alter the process. Safe fermentation usually begins at around two percent salt-to-water or salt-to-ingredients ratio. Under, and you risk the entire product spoiling.
Any other expert tips, flavor combinations, and recommendations for fermented hot sauce
Graves reminds new and old fermenters to lean into the experiment, the joys of letting things take their course, and the power of time and science, which are out of our control. She says, "Just have fun and experiment! It's all about the journey, and it's the kind of endeavor that requires letting go and not having total control. Personally I think this is good for a cook [to experience]!" Graves also encourages readers to consider more unlikely pairings, like scotch bonnet and quince. Graves' recipe for the fruity-meets-heat fermented hot sauce can be found in Pit Magazine's "The Sauce Special" issue.
Both Pao and Graves encourage fermenters to get creative and think outside the box. Graves says, "I also love adding it [fermented hot sauce] to cocktails, particularly something like a Bloody Mary." Graves also has a recipe for a fermented tomato and gochujang bloody Mary in her new book, "BBQ Days, BBQ Nights." "Just sub the gochujang for a spoonful of your fermented hot sauce," she adds.
For those seeking guidance in their experimentation, Liu leads in-person fermentation workshops. In addition to the resources both Liu and Graves extend to audiences, Liu recommends checking out "Fiery Ferments" by Kirsten Shockey for further inspiration.